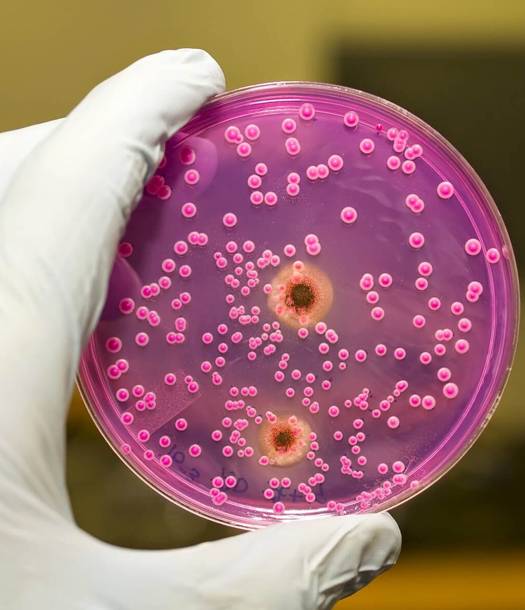

تمكن علماء في الصين والولايات المتحدة من اكتشاف وجود بكتيريا تتعايش مع البشر وتنتج نظيرا للإنزيم البشري DPP4، وهو معطّل لاستقلاب الغلوكوز عند الثديات ويطور سكري النوع 2، ومقاومة الأنسولين.
إنزيمات البكتيريا البشرية
وقال الباحثون المشاركون في هذه الدراسة : "لقد أنشأنا منصة خاصة لدراسة كيفية تأثير إنزيمات البكتيريا البشرية على فيزيولوجيا مضيفها. وأشارت تجاربنا إلى أن إنزيم DPP4، الذي تنتجه أنواع معينة من البكتيريا المعوية، يقلل من نشاط الجزيء GLP-1 الذي يقوم بتنظيم مستويات الأنسولين، ويسبب خللا في استقلاب الغلوكوز وفي زيادة نفوذية الأمعاء".
كيف تم الوصول إلى هذا الاكتشاف ؟
وتم التوصل إلى هذا الاستنتاج من قبل مجموعة من علماء الأحياء بقيادة الأستاذ في جامعة بكين، جيانغ تشانغتاو، أثناء مراقبة كيفية تأثير نفايات البكتيريا المعوية المختلفة على عمل جسم الفئران.
دراسة تأثير أنزيمات بكتيريا الأمعاء
وبذلك طوّر العلماء منصّة آلية تسمح لهم بزراعة أشكال مختلفة من بكتيريا الأمعاء البشرية ومراقبة تأثيرات إنزيماتها على عملية التمثيل الغذائي للفئران.
نتائج الدراسة
وخلصت التجارب إلى أن بعض أنواع البكتيريا البشرية أنتجت عددا كبيرا من جزيئات إنزيم DPP4 وهو مشابه جدا في التركيب للجزيء البشري الذي يحمل نفس الاسم.
ويتفاعل هذا البروتين مع جزيئات ببتيد GLP-1، أحد المنظمين الرئيسيين لعملية التمثيل الغذائي، الذي يتحكم في دوران الغلوكوز، وينظم إنتاج الأنسولين ويؤثر على حساسية الخلايا لهذا الهرمون.
ويحتوي كائن الثدييات على أنواع خلايا تبلغ أقل بحوالي 10 مرات مما تحتويه البكتيريا والفطريات وبعض النباتات الدقيقة.
ولفترة طويلة، ساد الاعتقاد عند الباحثين بأن تركيبته تؤثر بشكل أساسي على عملية التمثيل الغذائي، ولكن الملاحظات الأخيرة أشارت إلى أن خصائص تكوين البكتيريا الدقيقة تؤثر على احتمالية الإصابة بالسرطان وأمراض أخرى، وكذلك سلوك البشر والحيوانات.